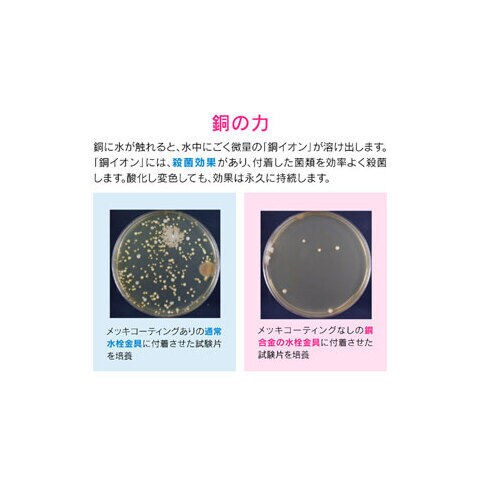

5/22
時点_ポイント最大6倍
GAONA 流し用排水プレート(銅製) ガオナ GA-PB002 【返品種別A】
販売価格
5,665
円 (税込)
送料無料
- 出荷目安:
- お取り寄せ
たまるdポイント(通常) 51
+キャンペーンポイント(期間・用途限定) 最大5倍
※たまるdポイントはポイント支払を除く商品代金(税抜)の1%です。
※表示倍率は各キャンペーンの適用条件を全て満たした場合の最大倍率です。
各キャンペーンの適用状況によっては、ポイントの進呈数・付与倍率が最大倍率より少なくなる場合がございます。
dカードでお支払ならポイント3倍
各キャンペーンの適用状況によっては、ポイントの進呈数・付与倍率が最大倍率より少なくなる場合がございます。
- 商品情報
- レビュー
【重要】お買い物前に必ずこちらをお読み下さい(外部リンク)
□「返品種別」について詳しくはこちら(外部リンク)□
□「返品種別」について詳しくはこちら(外部リンク)□
◆キッチンのシンク用の排水プレートです
◆排水口の内径145mmに取付できます
※購入前にはサイズを必ず確認してください。
◆銅の力
銅に水が触れると、水中にごく微量の「銅イオン」が溶け出します。
「銅イオン」には、殺菌効果があり、付着した菌類を効率よく殺菌します。酸化し変色しても、効果は永久に持続します。
◆殺菌効果のある銅製
銅イオンの殺菌効果で、ヌメリやにおいを防ぎます。
※使用を重ねるうちに黒ずんでいき、次第に薄青味がかった皮膜に変色しますが、銅イオンの殺菌効果は変わりませんので安心してお使いください。
◆排水カゴのゴミを隠してすっきり見せます
◆簡単交換
既存のフタを外して、取替えます。
■ 仕 様 ■
- 商品サイズ:幅160×高105×奥行190mm
- 商品重量:835g
- 包装形態:チャック袋
- 材質:銅